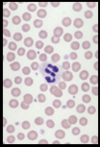
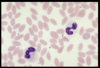
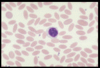

Hematology exam - Large Animal Flashcards
(38 cards)
Which large animal is a walking parasite?
Sheep and goat
Which large animal will you spend more time looking at blood?
Bovine
How long do you spin bovine blood?
10 min. because of the absence of rouleaux
Which cell be most commonly seen in Bovine?
Lymphocytes Inverted Neut : Lymph ratio
What color should plasma be for a cow?
Clear on dry feed Icteric on green feed
Name this WBC
Neutrophil
True or false
Rouleaux is usually absent in healthy cattle
True
What is rare to see in RBC?
Reticulocytes
What RBC can be common,often found in neonates, cannot be used for a test for lead poisoning?
Basophilic stippling
Where would you poke on a cow?
- Jugular
- Coccygeal
- subcutaneous abdominal
Mainly jugular
What are the breeds that blood values determine on?
Hot blooded
Cold blooded
Warm blooded
If you have a Hot blood (Arabian),what will you see on a blood smear?
Increase WBC and RBC
If you have a cold blooded (Draft), what would you see on a cbc or blood smear?
Decrease WBC and RBC
What shape are platelets in Horses?
Cigar shaped
What color is plasma in horses?
INTENSE YELLOW
What Large Animal has the lowest count of platelets in domestic animals?
Equine
Where are you going to poke a horse?
Jugular
ALWAYS POKE ON THE UPPER PORTION
What is most common cell seen in Horse?
Lymphocytes
Inverted Neut:Lymph ratio
What is the most common wbc seen in Caprine/goats?
Lymphocytes
Inverted Neut:lymph ratio
What is the size of RBC in Caprine/Goats?
Very small; 3.5 microns
Where are you going to poke on a goat?
Jugular
Cepharlic
Femoral
Auricular
What WBC will you commonly see on in a pig?
50:50 Neut: lymph ratio
What RBC morphology is normal?
Slight Poik
What problem is common in piglets?
Iron Deficiency Problems